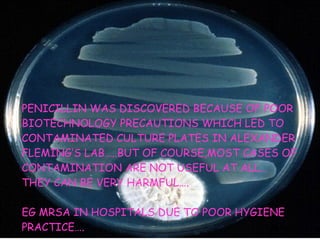
PENICILLIN WAS DISCOVERED BECAUSE OF POOR BIOTECHNOLOGY PRECAUTIONS WHICH LED TO  CONTAMINATED CULTURE PLATES IN ALEXANDER FLEMING’S LAB…..BUT OF COURSE,MOST CASES OF  CONTAMINATION ARE NOT USEFUL AT ALL… THEY CAN BE VERY HARMFUL…. EG MRSA IN HOSPITALS DUE TO POOR HYGIENE PRACTICE….

The document discusses biotechnology processes involving microorganisms like bacteria and yeast. It describes how these microbes are used to ferment sugars from various raw materials like grains and fruit juices to produce useful products. Through fermentation, bacteria convert sugars into alcohol, carbon dioxide, and other molecules. This process is used in food industries like baking, brewing, and dairy to produce items like bread, beer, and yogurt.